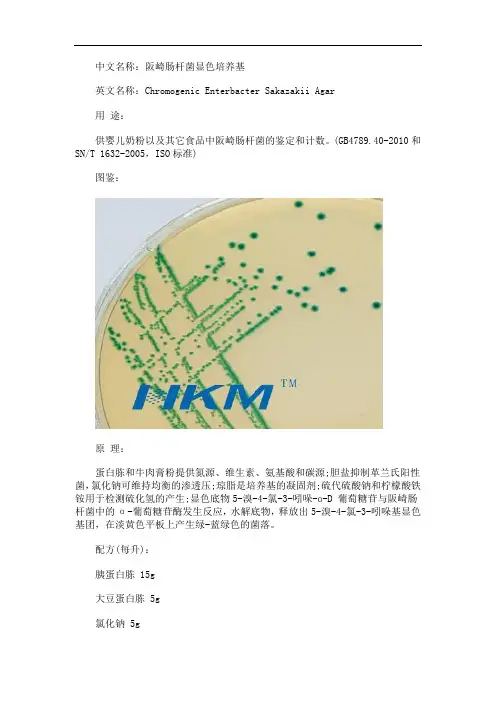

马拉色菌显色培养基说明书pdf
- 格式:pdf
- 大小:282.75 KB
- 文档页数:2

部分微生物培养基中英文对照大肠杆菌显色培养基E.Coli Chromogenic Medium大肠菌群显色培养基Coliform Chromogenic Medium大肠杆菌/大肠菌群显色培养基E.Coli/Coliform Chromogenic Medium 细菌总数显色培养基Total Genes Chromogenic MediumO157显色培养基O157 Chromogenic Medium沙门氏菌显色培养基Salmonella Chromogenic Medium李氏菌显色培养基Listera Chromogenic Medium金黄色葡萄球显色培养基Staphylococcus Chromogenic Medium霉菌和酵母菌显色培养基Mould and Yeast Chromogenic Medium弧菌显色培养基Vibrio Chromogenic Medium坂崎杆菌显色培养基Enterobacter sakazakii Chromogenic Medium平板计数琼脂(PCA)Plate Count Agar月桂基硫酸盐胰蛋白胨肉汤(LST)Lauryl Sulfate Tryptose Broth4-甲基伞形酮-D-葡萄糖醛酸苷(MUG)煌绿乳糖胆盐肉汤(BGLB) Brilliant Green Lactose Bile Brogh EC 肉汤 E.Coli Broth 新生霉素A伊红美蓝琼脂 (EMB)Eosin-Methylene Blue Agar营养肉汤 (NB) Nutrient Broth营养琼脂 (NA) Nutrient Agar乳糖胆盐发酵培养基 Lactose Bile Broth乳糖复发酵培养基 Lactose Broth去氧胆酸盐琼脂 Desoxycholate Lactose AgarMR-VP培养基 Methyl Red Voges Proskauer Broth结晶紫中性红胆盐琼脂 (VRBA) Violet Red Bile Agar西蒙氏枸橼酸盐琼脂 Simmons Citrate Agar肠道菌计数琼脂 (VRBDA) Violet Red Bile Dextrose Agar菌种保存培养基 Strain Store Medium品红亚硫酸钠琼脂 Fuchsin Basic Sodium Sulfite Agar乳糖蛋白胨培养液 Lactose Peptone BrothCary-Blair 氏运送培养基 Cary-Blair Transport Medium山梨酸麦康凯琼脂基础 Sorbitol Maconkey Agar Base 噻孢霉素 A 1%亚碲酸钾溶液亮绿乳糖培养基 Brilliant Green Lactose Medium肠道菌增菌肉汤(EE) Enterobacteria Enrichment BrothTTC营养琼脂 TTC Nutrient Agar LB肉汤 LB BrothLB营养琼脂 LB Nutrient Agar苯丙氨酸脱氨酶培养基 Phenylalanine Deaminase Agar Medium哥伦比亚血琼脂基础Columbia Blood Agar Base2216E琼脂2216E Agar 肠球菌琼脂(胆盐-七叶苷-叠氮钠琼脂) Enterococcosel Agar(Bile Esculin Azide Agar)BDS培养基BDS Medium 葡萄糖琼脂Dextrose AgarAndrade氏糖类肉汤Andrade's Carbohydrate BrothKoser氏枸椽酸盐肉汤Koser Citrate Sodium BrothEndo 培养基Endo Agar 缓冲MUG琼脂Buffer MUG Agar乳糖莫能霉素葡萄糖醛酸琼脂LMG Agar茜素-β-半乳糖苷琼脂Aliz-gal Agar Tergitol-7 琼脂Tergitol-7 Agar TTC 溶液(0.125%)TTC Solution(0.125%)胰蛋白胨大豆肉汤 Trypticase (Tryptic) Soy BrothBaird-Parker琼脂基础 Baird-Parker Agar Base亚碲酸盐卵黄增菌液 Egg-Yolk Tellurite Emulsion胰蛋白胨大豆肉汤 Trypticase (Tryptic) Soy BrothBaird-Parker琼脂基础 Baird-Parker Agar Base亚碲酸盐卵黄增菌液 Egg-Yolk Tellurite Emulsion兔血浆 Freeze-Dried Plasma DNA酶琼脂 DNase Agar#p#分页标题#e#7.5%氯化钠肉汤 7.5% Sodium Chloride Broth 普通肉汤培养基 Broth Medium亚碲酸钠肉汤培养基基础 Sodium Tellurite Broth Base葡萄球菌增菌肉汤 Staphylococcus Enrichment Broth葡萄球菌选择性琼脂 Staphylococcus Selective AgarEEM培养基EEM medium 甘露醇高盐琼脂 Manitol Salt Agar肠毒素产毒培养基TMP琼脂培养基缓冲蛋白胨水(BPW) Buffered Peptone Water亚硒酸盐胱氨酸增菌液(SC) Selenite Cystine Broth四硫磺酸盐煌绿增菌液基础(TTB)Tetrathionate Broth Base胆硫乳琼脂(DHL) Deoxycholate Hydrogen Sulfide Lactose Agar三糖铁琼脂(TSI) Triple Sugar Iron Agar SS 琼脂 Salmonella Shigella Agar 亚硫酸铋琼脂(BS) Bismuth Sulfite Agar亚利桑那菌琼脂(SA) Salmonella Arizona Agar氯化镁孔雀绿肉汤(MM,RV Medium) Rappaport-Vassiliadis MdeiumHE 琼脂(HE) Hekton Enteric Agar赖氨酸脱羧酶培养基 Lysine-decarboxylase Test Broth尿素酶琼脂基础 Urease Agar Base 40%尿素水 40%Urea WaterV-P 半固体琼脂 Voges-Proskauer Semisolid Agar吲哚培养基 Indole Medium Kovacs氏靛基质试剂盒硝酸盐氰化钾培养基基础 Nitrate(KCN) Broth Base丙二酸钠培养基 Malonate Broth 卫矛醇半固体琼脂 Dulcitol Semisolid AgarGN 增菌液 Gram Negative Enrichment BrothXLD 培养基 Xylose Lysine Desoxycholate Medium WS 琼脂 WS Salmonella Agar 葡萄糖铵培养基 Ammonium Dextrose Medium葡萄糖半固体培养基 Dextrose Semisolid Medium动力-吲哚-尿素培养基基础(MIU) Motility Indol Urea Medium Base亚硒酸盐增菌液(SF) Selenite Enrichment Medium醋酸铅培养基 Lead Acetate MediumSIM培养基 Hydrogen Sulfide Indole Motility Medium乳糖肉汤 Lactose Broth EF-18 琼脂EF-18 Agar 新生霉素碱性蛋白胨水 Alkaline Peptone WaterTCBS琼脂 Thiosulfate Citrate Bile Salts Sucrose Agar氯化钠多粘菌素B肉汤基础(SCPB) Sodium Chloride Polymyxin Broth Base多粘菌素B 庆大霉素琼脂 Gentamycin Agar 四号琼脂基础 No.4Agar Base我妻氏培养基基础 Wagstsuma Agar Base60%/L氯化钠蛋白胨肉汤 60%/L NaCl Peptone Water氯化钠三糖铁 NaCl Triple Sugar Iron Agar胰胨大豆琼脂斜面(TSA) Trypcasein Soy Agar42℃生长培养基42℃growth Medium O/F培养基(HLGB) O/F Medium氯化钠结晶紫增菌液 Sodium Chloride Violet purple Enrichment Broth氯化钠蔗糖琼脂 Sodium Chloride Sucrose Agar 嗜盐菌选择性琼脂氯化钠血琼脂基础 Sodium Chloride Blood Agar Base霍乱双糖铁琼脂(KIA) 副溶血性弧菌琼脂副溶血性弧菌增菌液T1N1 琼脂 T1N1 Agar T1N0 肉汤 T1N0 Broth T1N3 肉汤 T1N3 Broth精氨酸葡萄糖斜面琼脂 Arginine Dextrose Agar精氨酸双水解酶试验用培养基(AD) mCPC 培养基mCPC Medium mCPC培养基添加剂mCPC Medium Supplement察氏琼脂 Czapek Dox Agar 产毒培养基 Toxin-Producing Medium#p#分页标题#e# 马铃薯葡萄糖琼脂 (PDA) Potato Dextrose Agar高盐察氏琼脂 Salt Czapek Dox Agar 沙氏琼脂培养基 Sabouraud's Agar改良沙氏琼脂培养基 Sabouraud's Agar,Modified玉米粉琼脂 Corn Meat Medium 孟加拉红培养基 Rose Bengal Medium菌种培养基 Strain Medium(for B.Cereus)四环素检定琼脂 Tetracyline Examination Agar亚硫酸盐琼脂 Sulfite Agar 亚硫酸铁琼脂Iron Sulfite Agar 布氏肉汤 Brucella Broth改良Skirrow氏琼脂基础 Skirrow Agar Base,Modified改良Camp-BAP氏琼脂基础Camp-BAP Agar Base,ModifiedTTC 琼脂基础 TTC Agar Base 甘氨酸培养基 Glycine Medium快速硫化氢试验琼脂 H2S Test MediumDNA酶甲基绿琼脂基础 DNase Agar Base with Methyl Green马尿酸钠培养基快速硫化氢(H2S)试验琼脂CCDA基础CCDA Base CCDA添加剂CCDA SupplementCampy-Cefex 琼脂基础Campy-Cefex Agar BaseCampy-Cefex 添加剂Campy-Cefex Supplement甘露醇卵黄多粘菌素琼脂基础(MYP) -Egg-Yolk-Polymyxin Agar Base胰酪胨大豆多粘菌素肉汤基础 Trypticase-Soy-Polymyxin Broth Base改良V-P培养基 Medium,Modified胰酪胨大豆羊血琼脂基础 Trypticase Soy Sheep Blood Agar Base酪蛋白琼脂 Casein Agar酚红葡萄糖肉汤硝酸盐肉汤动力-硝盐培养基木糖-明胶培养基胰月示-亚硫酸盐-环丝氨酸琼脂基础 (TSC)Tryptose Sulfite Cycloserine Agar Base D-环丝氨酸产芽孢肉汤 Sporulation Broth亚硫酸盐-多粘菌素-磺胺嘧啶琼脂基础 Sulfite-Polymyxin-Sulphadiazine Agar Base 多粘菌素B 多价蛋白胨-酵母膏 (PY) 培养基 Poly Peptone Yeast Extract Medium 疱肉培养基基础 Cooked Meat Medium Base 疱肉牛肉粒 Dried Meat Particle液体硫乙醇酸盐培养基 Thiolglycollate Medium(Agar-free)卵黄琼脂培养基基础 Egg Yolk Agar Base 动力-硝酸盐培养基含铁牛奶培养基葡萄糖肉浸液肉汤 Dextrose Meat Infusion Broth匹克氏肉汤基础A Pick's Broth BaseA 肉浸液肉汤培养基 Meat Infusion Broth叠氮钠葡萄糖肉汤 Aziode Dextrose Broth 乙基紫叠氮钠肉汤 Ethyl Violet Aziode Broth KF链球菌琼脂 KF Streptococcus Agar LIM培养基LIM MediumCIN-1I培养基基础 Cepulodin Irgasan Novobiocin Agar改良Y培养基 Agar,Modified 改良磷酸盐缓冲液PSB Phosphate Saline Buffer,Modified 0.5%葡萄糖肉汤培养基 0.5% Dextrose Broth溴甲酚紫葡萄糖蛋白胨水培养基 Glucase Peptone Water Medium改良番茄汁培养基 Tomato Juice Agar,Modified改良MC培养基 Chalmers Agar ,Modified MRS 琼脂基础MRS Agar BaseLBS 琼脂LBS agar胰酪胨大豆酵母浸膏肉汤(TSB-YE) Trypticase Soy-Yeast Extract Broth萘啶酮酸吖啶黄素放线菌酮胰酪胨大豆酵母浸膏琼脂(TSA-YE) Trypticase Soy-Yeast Extract Agar李氏菌选择性培养基基础(MMA) Modified Mcbride Agar Base复达欣糖发酵基础肉汤 Bromcresol Purple Broth Base#p#分页标题#e#李氏菌增菌肉汤(LB1,LB2)基础 Listeria Enrichment Broth Base萘啶酮酸萘啶酮酸吖啶黄素吖啶黄素七叶苷培养基 Esculin Medium 半固体动力培养基 Motility Test Medium(Semisolid) 牛津琼脂(OXA)基础 Oxford Agar Base多粘菌素E 放线菌酮溴甲酚紫葡萄糖肉汤 Bromcresol Purple Dextrose Broth 酸性肉汤 Acid Borth 麦芽浸膏汤 Malt Extract Broth锰盐营养琼脂 Mn2+Nutrient Agar 疱肉培养基基础 Cooked Meat Medium Base卵黄琼脂基础 Egg Yolk Agar Base 疱肉牛肉粒 Dried Meat ParticleUBA 培养基UBA Medium NBB 培养基NBB AgarMRS 琼脂基础MRS Agar Base Raka-Ray 培养基Raka-Ray MediumSCDLP液体培养基 Soya Casein Digest Lecithin Polysorbate Broth卵磷脂吐温80营养琼脂 Lecithin Tween 80 Nutrient Agar乙酰胺琼脂 Acetamide Agar 十六烷三甲基溴化铵琼脂 Cetrimide Agar甘露醇发酵培养基 Mannitol Medium 明胶培养基基础 Gelatin Medium Base绿脓菌素测定培养基 King Medium A 乳糖胆盐培养基 Lactose Bile MediumTTC卵磷脂-吐温80-营养琼脂 TTC Lecithin Tween80 Nutrient Agar液体硫乙醇酸盐培养基 Thioglycollate Medium液体硫乙醇酸盐培养基(不含琼脂) Thioglycollate Medium (without Agar)真菌培养基 Fungi Medium YPD琼脂 Yeast Peptone Dextrose Agar抗生素检定培养基1号(高PH) Antibiotic Agar No.1抗生素检定培养基1号(低PH) Antibiotic Agar No.1抗生素检定培养基2号(高PH) Antibiotic Agar No.2抗生素检定培养基2号(低PH) Antibiotic Agar No.2抗生素检定培养基3号 Antibiotic Agar No.3 胆盐乳糖增菌液 Bile Lactose Broth 玫瑰红钠琼脂 Rose Bengal Medium 0.5%葡萄糖肉汤培养基 Broth Medium肉汤琼脂培养基 Broth Agar Medium 普通琼脂斜面培养基(Ph8.0-8.2)甘露醇高盐琼脂 Manitol Salt Agar 酪胨琼脂 Peptone from Casein Agar葡萄糖蛋白胨培养基 Dextrose Peptone Medium抗生素检定培养基4号 Antibiotic Agar No.4抗生素检定培养基6号 Antibiotic AgarNo.6抗生素检定培养基7号 Antibiotic Agar No.7抗生素检定培养基8号 Antibiotic Agar No.8卵黄高盐琼脂基础 Egg-Yolk Salt Agar Base抗生素5号 Antibiotic No.5MUG培养基 MUG Medium 真菌琼脂培养基 Fungi Agar Medium磷酸盐葡萄糖胨水培养基 Phosphate Glucose Peptone Water Medium甲基红批示剂盒胰蛋白胨水培养基 Peptone Water MediumKovacs氏靛基质试剂盒硝酸盐胨水培养基 Nitrate Saline Peptone Water Medium#p#分页标题#e#硝酸盐还原试剂盒抗生素检定培养基3号 Antibiotic Agar No.3改良马丁液体培养基 Martin Broth ,Modified改良马丁琼脂培养基 Martin Agar Medium ,Modified 庆大霉素琼脂 Gentamycin Agar MH 肉汤(MHB) Mueller-Hinton Broth MH 琼脂(MHA) Mueller-Hinton Agar中国蓝琼脂 China Blue Agar 克氏双糖铁琼脂 Kligler Iron Agar血液琼脂基础 Blood Agar Base 血液增菌培养基 Blood Enrichment Medium氯化三苯四氮唑-沙保罗培养基 TTC-Sabourand's Medium 麦康凯琼脂 Maconkey Agar 麦康凯琼脂2号 Maconkey Agar No.2 麦康凯琼脂3号 Maconkey Agar No.3碱性琼脂平板 Alkaline Agar 碱性胆盐琼脂 Alkaline Bile Salt Agar 胰膘肉汤基础 Tryptose Broth Base 豆粉琼脂(血琼脂基础) Blood Agar Base赫氏培养基赫氏增菌液溶血琼脂基础亚硫酸钠琼脂 Sulfite Agar 龙胆紫血液琼脂基础叠、红、碲、铜琼脂硫酸十二烷基钠琼脂改良罗氏培养基基础 L-G medium Base,modified酸性L-G培养基基础碱性L-G培养基基础 PNB(对硝基苯甲酸)TCH(噻吩-2-羧酸酰肼)戊烷脒多粘菌素B琼脂基础碳酸氢钠琼脂基础指示选择性培养基基础 PLET 琼脂基础戊烷脒炭疽杆菌疫苗炭疽杆菌沉淀血清炭疽杆菌噬菌体炭疽杆菌诊断抗原青霉素敏感纸片印度墨汁碘伏(液体)溶菌酶美蓝(亚甲基蓝)水杨素醋酸盐琼脂Acetate Agar 气单胞菌鉴别琼脂 Aeromonas Differential Agar厌氧菌琼脂Anaerobic Agar APT 琼脂APT Agar曲霉素琼脂基础(AFPA) 腊样芽胞杆菌选择琼脂基础Bacilus Cereus Selective Agar Base 去氧胆酸盐枸椽酸盐乳糖蔗糖琼脂DCLS Agar去氧胆酸盐枸椽酸盐琼脂Desoxycholate Citrate AgarFraser 培养基Fraser Medium Fraser 添加剂Fraser SupplementUVM培养基UVM Medium UVM 添加剂1UVM Supplement1UVM 添加剂2UVM Supplement2 假单胞分离琼脂Pseudomonas Isolation Agar假单胞分离肉汤Pseudomonas Isolation Broth 水琼脂培养基Water Agar肌醇测定培养基Inositol Assay Broth 烟酸测定培养基Vitamin PP Assay Broth 叶酸测定培养基Folic Acid Assay Medium泛酸测定培养基Pantothenic Acid Assay Medium#p#分页标题#e#游离生物素测定培养基Free Biotin Assay Medium气单胞菌培养基基础Aeromonas Medium Base(Ryan)气单胞菌培养基添加剂Ampicillin Selective Supplement LES Endo 琼脂Endo Agar,LES 支原体培养基基础Mycoplasma Broth Base梭菌琼脂Clostridium Agar梭菌鉴别肉汤Clostridium Differential Broth梭菌选择琼脂Clostridium Selective Agar胰蛋白胨大豆琼脂Tryptose Soya Agar布氏菌选择性培养基Brucella Selective Medium 细菌蛋白胨Peptone Bacterial 胰蛋白胨 Tryptone酪蛋白胨 Peptone from Casein植物(大豆)蛋白胨 Peptone from soy月示胨Proteose peptone 多价蛋白胨Polypeptone特殊蛋白胨Peptone Special 牛心浸粉Beef Heart Infusion肝浸粉Liver Infusion 牛肉浸粉 Beef Extract Powder酵母浸粉 Yeast Extract Powder酸水解酪蛋白Casein acid Hydrolysate细菌琼脂粉 Bacterial Agar 牛胆盐Bile Salt 三号胆盐No. 3 Bile Salt。

化学品安全技术说明书第一部分化学品及企业标识产品中文名称:改良MRSV培养基配套试剂产品英文名称:Additives for Modified Semi-solid Rappaport VassiliadisMedium产品编号:SR0530企业名称:广东环凯微生物科技有限公司地址:广东省广州市黄埔区广州开发区科学城神舟路788号邮编:510663公司网址电子邮件地址:*********************传真号码:************销售热线:************-8602技术热线:************-8877/8876推荐用途和限制用途:生化研究/分析第二部分危险性概述GSH危害性类别非危险混合物。
.GSH标签要素无。
物理和化学危险无数据资料。
健康危害无数据资料。
环境危害无数据资料。
其它危害无。
第三部分成分/组成信息混合物化学品成分:参考产品说明。
有害物质成分:无第四部分急救措施一般信息:无特殊的措施要求。
皮肤接触:立即用清水彻底清洗。
眼睛接触:立即提起眼睑,用大量流动清水冲洗。
如不适就医。
吸入:如不适就医。
食入:如不适就医。
就医信息:出示产品使用说明或者此SDS。
第五部分消防措施危险特性:不助燃有害燃烧产物:一氧化碳,二氧化碳,氮的氧化物。
灭火方法及灭火剂:选用适合周围火源的灭火器。
水,泡沫,二氧化碳,干粉,沙土。
灭火注意事项:防止气体吸入。
第六部分泄露应急处理个人防护:穿个人实验服,佩戴手套和口罩,避免吸入干粉。
环境保护措施:用湿布和地拖擦拭干净。
清洁/收集措施:保持干燥。
迅速清洗弄脏的区域。
额外信息:无有害物质泄漏。
第七部分操作处置与储存操作注意事项:无特殊的措施要求。
储存条件:4-8℃储存注意事项:贮存于避光、干燥处。
第八部分接触控制/个人防护职业接触限值没有已知的国家规定的暴露极限。
工程控制:提供安全淋浴和洗眼设备个人保护措施呼吸系统防护:在通风橱里称取产品,佩戴口罩。

念珠菌显色对照培养基念珠菌显色对照培养基用途:培养基适用性实验念珠菌显色对照培养基外观:本品为淡黄色均一粉末,加入水中混悬均匀,灭菌后融化状态时为黄色透明液体。
念珠菌显色对照培养基酸度:灭菌后pH6.0.念珠菌显色对照培养基注意事项:1.检查平板内是否干裂或染菌,如长菌请勿使用;2.请在洁净的环境下操作,避免杂菌干扰;3.在冰箱储存很久的培养基容易出现一些冷凝水,请在洁净的环境下将水倒出,然后在培养箱放置10-30Min,待其表面干燥后再接种;或在使用前,提前一到两周放置室温即可;4.弃物处理:使用后应高压灭菌或焚烧后按一般垃圾处理,也可按专业技术人员指示方法处理。
保存:避光保存,放于阴凉干燥处。
念珠菌显色对照培养基他相关对照培养基:硫乙醇酸盐流体对照培养基改良马丁对照培养基营养琼脂对照培养基营养肉汤对照培养基玫瑰红钠琼脂对照培养基胆盐乳糖对照培养基甘露醇氯化钠琼脂对照培养基沙氏葡萄糖肉汤对照培养基麦康凯琼脂对照培养基沙门、志贺菌属琼脂对照培养基4-甲基伞形酮葡萄苷酸(MUG)对照培养基沙氏葡萄糖琼脂对照培养基念珠菌显色对照培养基绿脓菌素测定用对照培养基基础梭菌增菌对照培养基哥伦比亚琼脂对照培养基溴化十六烷基三甲铵琼脂对照培养基基础四硫磺酸钠亮绿对照培养基基础乳糖发酵对照培养基酵母浸出粉胨葡萄糖琼脂(YPD)对照培养基胰酪大豆胨琼脂对照培养基胰酪大豆胨肉汤对照培养基R2A琼脂对照培养基三糖铁琼脂对照培养基麦康凯液体对照培养基紫红胆盐葡萄糖琼脂对照培养基肠道菌增菌液体对照培养基木糖赖氨酸脱氧胆酸盐对照培养基。

法国科玛嘉MRSA显色培养基使用说明书此培养基用于耐甲氧西林金葡的分离和鉴定。
一、组分琼脂15.0g/L蛋白胨﹑酵母浸出物及盐分65.0g/L色素 2.5g/LpH 6.9±0.2根据需要,可以进行经典配方的调整或补充。
二、操作1.取瓶内干粉,每8.25 g溶于100ml蒸馏水或纯水中,可以根据需要按照比例扩大、缩小。
2.将上述干粉缓慢倒入蒸馏水中,充分搅拌溶解。
3.加热至100℃,并按常规不断搅拌。
如果使用高压锅,无需加压,加热不能超过100℃。
混合物也可以在微波炉中加热,用此法加热,煮沸后混合物立即移出微波炉并轻轻搅拌,而后移入微波炉再加热,直至琼脂完全溶解(大量气泡代替泡沫产生,大约需要2分钟)。
4.取增补剂一瓶加入20ml无菌水中(可根据需要按照基础培养基的比例扩大或缩小)使其完全溶解。
5.★使用倾注程序:将培养基水浴冷却至50℃左右,然后把混匀后的增补剂加入到冷却好的基础培养基中,轻轻混匀,准备无菌带盖培养皿,每个培养皿接种1ml 样品,然后倾注10ml上述溶解的培养基,混匀使其凝固,倒置,37℃培养24小时。
★如果用表面接种程序:将混匀后的培养基倾注于无菌培养皿中,使其凝固,在室温可保存一天或在冰箱里贮存数天(避光,2-8℃)。
划线接种(在冰箱中贮存的培养皿/试管应先恢复至室温才可以接种),倒置,37℃培养24小时。
三、储存1.干粉需保存在15-30℃,干燥环境中。
2.增补剂需保存在2-8℃环境下。
四.结果初筛微生物菌落色彩耐甲氧西林金黄色葡萄球菌(MRSA)青霉素敏感金葡菌(MSSA)其他紫红色不生长被抑制、无色或兰色注:最后的鉴定必须做补充实验。
★使用过的培养基需要在121℃灭菌至少20分钟才可以按照有关规定丢弃。
CHROM agar公司中国区特约经销商:北京赛为思生物技术开发中心。

科玛嘉假单胞菌显色培养基使用说明书
此培养基用于假单胞菌的分离和鉴定
一、组分(g/L)
蛋白胨、酵母浸出物 8.0
盐类 8.0
色素 2.2
琼脂 15.0
PH 7.5±0.2
二、操作
1、取瓶内干粉,溶于1000ml蒸馏水或纯水中,可根据需求按33.2g/L的比例扩大、缩小。
2、将上述干粉缓慢倒入蒸馏水中,充分搅拌溶解。
3、加热至100℃并按常规不断搅拌。
混合物也可以在微波炉中加热,用此法加热,煮沸后混
合物立即移出微波炉并轻轻搅拌,而后移入微波炉再加热,直至琼脂完全溶解(大量气泡代替泡沫产生,大约需要2分钟)。
4、将培养基水浴冷却至48℃,倾注于已灭菌的培养皿中,使其凝固,
三、接种
划线接种(如果培养基刚从冰箱中取出,要恢复至室温后才能使用),30℃培养24小时,部分敏感的假单胞菌需要延长培养至48h。
三、贮存
1.干粉需保存在15-30℃干燥环境中。
2.倾注好的培养基在室温可保存一天,2/8℃冰箱中避光可以贮存两星期。
五、结果
初筛微生物菌落色彩
假单胞菌蓝绿色
其他其他颜色,无色或被抑制注:最后的鉴定必须通过补充试验。
★使用过的培养基需要在121℃灭菌至少20分钟才可以按照有关规定丢弃
CHROM agar公司中国区特约经销商:北京赛为思生物技术开发中心。
![[高等教育]马丁氏培养基](https://uimg.taocdn.com/567d23cfa48da0116c175f0e7cd184254b351b36.webp)
实验二十一马丁氏培养基的制备一、目的要求通过对分离真菌用的马丁氏(Martin)培养基配制,掌握对选择培养基的配制方法,并明确选择的原理。
二、基本原理马丁氏培养基是一种用来分离真菌的选择性培养基。
此培养基是由葡萄糖、蛋白胨、KH2PO4、MgSO4·7H2O、孟加拉红(玫瑰红,Rose Bengal)和链霉素等组成。
其中葡萄糖主要作为碳源,蛋白胨主要作为氮源,KH2PO4和MgSO4·7H2O作为无机盐,为微生物提供钾、磷和镁离子。
而孟加拉红和链霉素主要是细菌和放线菌的抑制剂,对真菌无抑制作用,因而真菌在这种培养基上可以得到优势生长,从而达到分离真菌的目的。
马丁氏培养基配方如下:KH2PO4 1gMgSO4·7H2O 0.5g蛋白胨5g葡萄糖10g琼脂15—20g水1000mlpH 自然此培养液1000ml加1%孟加拉红水溶液3.3ml。
临用时每100ml培养基中加1%链霉素液0.3ml。
三、器材KH2PO4,MgSO4·7H2O,蛋白胨,葡萄糖,琼脂,孟加拉红,链霉素;试管,三角烧瓶,量筒,玻棒,培养基分装器,扭力天平,牛角匙,高压蒸汽灭菌锅等。
四、操作步骤1.称量和溶化按培养基配方,准确称取各成分,并将各成分依次溶化在少于所需要的水量中。
待各成分完全溶化后,补足水分到所需体积。
再将孟加拉红配成1%的溶液,在1000ml培养液中加入1%的孟加拉红溶液3.3ml,混匀后,加入琼脂加热溶化(方法同实验十九)。
2.分装、加塞、包扎、灭菌,无菌检查与实验十九相同。
3.链霉素的加入由于链霉素受热容易分解,所以临用时,将培养基溶化后待温度降至45℃左右时才能加入。
可先将链霉素配成1%的溶液,在100ml培养基中加1%链霉素液0.3ml,使每毫升培养基中含链霉素30μg。
五、实验报告思考题(1)什么是选择培养基?它在微生物学工作中有何重要性?(2)培养细菌、放线菌、酵母菌、霉菌的最适pH值各为多少?。


马拉色菌介绍及说明一、菌属分类特征马拉色菌属(Malassizia spp.)属于半知菌,丝孢菌纲,丝孢菌目,丛梗孢科。
马拉色菌属是一种嗜脂酵母,是人体表面的一种正常菌群,在某些因素的影响下也可作为病原菌引起疾病。
通过形态学、生化学和分子生物学方法目前国际上公认的将马拉色菌属分成了7个种:厚皮马拉色菌(M.pachydermatis)、糠秕马拉色菌(M.furfur)、球形马拉色菌(M.globosa)、合轴马拉色菌(M.sympodialis)、钝形马拉色菌(M.obtuse)、限制马拉色菌(M.restricta)、斯洛菲马拉色菌(M.sloofiae)。
二、致病性除厚皮马拉色菌外,其他6个种与正常皮肤菌丛和花斑癣损害有关。
球形马拉色菌是马拉色菌毛囊炎主要病原菌;有报道马拉色菌与脂溢性皮炎、特应性皮炎、银屑病、皮肤垢着症等有关。
深部感染少见,主要见于静脉高营养者,且主要为儿童。
三、生物学特性该菌具有嗜脂性,除厚皮马拉色菌可以在沙堡培养基上生长外,只在含有长链脂肪酸的培养基上生长。
菌落在Dixon培养基和改良花斑癣培养基上生长良好,并且最佳生长温度为34℃或37℃。
菌落孵育4天后开始生长,菌落逐渐增大形成乳白色酵母样菌落,颜色逐渐变成黄、褐黄色。
四、属内菌种的鉴定(一)直接镜检KOH或墨水涂片直接光镜下观察,马拉色菌属的孢子呈成群、厚壁、圆形或卵圆形,直径约3~8μm,亦可见芽生孢子,为单极出芽,芽颈宽窄不一;菌丝粗短、弯曲或弧形,一端较钝。
(二)生化试验马拉色菌属芽管试验、碳水化合物同化实验、碳水化合物发酵试验结果均为阴性。
沙堡培养试验用于鉴定厚皮马拉色菌,它是唯一非嗜脂的马拉色菌,可以在沙堡培养基上生长。
过氧化氢酶试验用于鉴定限制性马拉色菌,它是唯一的过氧化氢酶试验阴性的马拉色菌。
七叶苷分解试验通过观察培养基的颜色如变黑至少1/3的为合轴马拉色菌和钝形马拉色菌,糠秕马拉色菌只能使培养基的顶端变黑或为阴性,斯洛非、球形和限制马拉色菌为阴性。

念珠菌显色培养基产品技术要求
念珠菌显色培养基是一种用于分离和鉴定念珠菌的培养基。
其技术要求包括以下几个方面:
1. 组成成分:念珠菌显色培养基的基本组成成分包括碳源、氮源、无机盐、生长因子和显色剂。
其中,碳源可以选择葡萄糖或麦芽糖,氮源可以选择酵母提取物或蛋白胨,无机盐可以选择磷酸盐、硫酸盐等,生长因子可以选择维生素、氨基酸等,显色剂通常选择溴甲酚绿或溴甲酚蓝等。
2. pH值:念珠菌显色培养基的pH值一般控制在5.6-6.0之间,以利于念珠菌的生长。
3. 抑制其他细菌和真菌的添加物:为了避免其他细菌和真菌的污染,一般在念珠菌显色培养基中添加适量的抗生素,如青霉素、链霉素等。
4. 显色机制:念珠菌显色培养基的显色机制是通过将念珠菌菌落显色为特定的颜色。
常见的显色剂有溴甲酚绿和溴甲酚蓝,分别会使念珠菌菌落显色为绿色和蓝色。
5. 储存条件:念珠菌显色培养基的储存条件应为干燥、阴凉和避光,以保持其营养物质的稳定性。
总之,念珠菌显色培养基产品的技术要求包括合理的组成成分、适宜的pH值、抗菌剂的添加、明确的显色机制和适宜的储存条件等。
这些要求有助于提高显色培养基的质量和稳定性,从而准确分离和鉴定念珠菌。

专注微生物监测控制为食药安全保驾护航广东环凯微生物科技有限公司网址: 地址:广州市黄埔区科学城神舟路788号邮编:510663传真:************-8619销售热线:************转8602(分机)技术热线:************转8876、8877(分机)产品说明书Product Manual【产品名称】通用名称:李斯特氏菌显色培养基英文名称:Listeria Chromogenic Media【产品编号与包装规格】产品编号产品类型包装规格CRM014基础干粉1000mL 配制用量/瓶SR0470A 李斯特氏菌显色培养基配套试剂A(固体)2g/瓶二选一SR0470C 李斯特氏菌显色培养基配套试剂C(液体)10支/盒(2mL/支)SR0470李斯特氏菌显色培养基配套试剂B(冻干)10支/盒【产品用途】用于分离和初步鉴别单增李斯特氏菌和其它李斯特氏菌。
【检验原理】蛋白胨、大豆胨和酵母膏粉提供碳氮源和微量元素;氯化钠维持均衡的渗透压;琼脂是培养基的凝固剂;显色剂与李斯特氏菌具有的酶发生特异性反应,水解底物,释放出显色基团,李斯特氏菌形成绿色菌落周围有晕圈;配套试剂B 可抑制杂菌的生长。
方法1(CRM014基础干粉+SR0470+SR0470A):称取本品71.1g,加入910mL 纯化水,搅拌加热至完全溶解;另外将SR0470A 李斯特氏菌显色培养基配套试剂A(固体)移到三角瓶中,加入80mL 纯化水,充分混匀成均一悬浊液(可借用磁力搅拌器或涡漩混合器)。
基础培养基和SR0470A 分别单独121℃高压蒸汽灭菌15min,冷至约50℃备用。
取80mL SR0470A 和10支SR0470加入到910mL 已灭菌基础培养基中(可按比例扩增或缩小),充分混匀倾注无菌平皿,待凝固,备用。
方法2(CRM014基础干粉+SR0470+SR0470C):称取本品71.1g,加入970mL 纯化水,搅拌加热至完全溶解,121℃高压蒸汽灭菌15min,冷至约50℃备用。
显色培养基显色培养基(Chromogenic/Fluorogenic Culture Media)是一类利用微生物自身代谢产生的酶与相应显色底物反应显色的原理来检测微生物的新型培养基。
这些相应的显色底物是由产色基因和微生物部分可代谢物质组成,在特异性酶作用下,游离出产色基因显示一定颜色,直接观察菌落颜色即可对菌种作出鉴定。
它是一种新型分离培养基,利用显色培养基进行微生物的筛选分离,其反应的灵敏度和特异性大大优于传统培养基。
大肠杆菌显色培养基E.Coli Chromogenic Medium用途:用于快速、准确检测大肠杆菌大肠杆菌培养24小时,大肠杆菌显蓝绿色大肠杆菌显色培养基是青岛海博生物公司改良的培养基,用于食品、水、牛奶、冰激凌和肉制品中大肠杆菌的快速检测。
大肠杆菌显蓝绿色,大肠菌群显无色,其它菌显黄色或无色,革兰氏阳性菌被抑制。
成份(g/L)此配方可以进行改良或增加营养成份以获得最佳的结果。
注意此培养基仅供实验室使用。
用法称取本品50.1g 加入1000ml 蒸馏水,加热溶解并不停搅拌,煮沸不要超过1 分钟。
分装三角瓶,121 ℃高压灭菌15 分钟。
取1ml 制备好的样品液加入直径为9cm 无菌平皿中心,倾入冷却至45 -50 ℃培养基约15ml ,混匀,凝固后,36 ± 1 ℃倒置培养18 ~24h 。
或冷却至45-50 ℃时,倾入无菌平皿,琼脂完全凝固后,在37 ℃的培养箱中倒置放置1-2 小时,加入适当稀释度的样品液1ml ,涂布于培养基上,36 ± 1 ℃培养18 ~24h 。
贮存制备好的平板应立即使用,应避免光线直接照射。
干燥培养基应放置于阴暗干燥处,保存温度2-8 ℃,注意避光保存。
失效干燥培养基超过保质期、结块和颜色变化都不能使用。
操作步骤1 、按国家标准、SN 标准、FDA 标准或其它方法制备样品液2 、取样品液1ml 加入冷却至45-50 ℃显色培养基中混匀或涂布于平板上3 、36 ± 1 ℃培养18 ~24h ,选用有30 ~200 个菌落的平板,计数平板上出现的典型大肠杆菌菌落。
显色培养基快速检测大肠菌群和大肠杆菌效果的研究卢勉飞吴清平蔡芷荷何天文【摘要】目的评价大肠菌群(coz扣珊)和大肠杆菌(西ck廊^玩c0如)复合显色培养基(ccEA)的检测效果。
方法本实验室研究的显色培养基ccEA与经典培养基结晶紫中性红胆盐琼脂培养基(VRBA)和国外两种同类商品化显色培养基(AgarI和AgarⅡ)作对比,分别对11种质控菌株、添加大肠杆菌或大肠菌群的13种无菌样品以及4种实际样品进行检测,对检测结果进行统计分析,以及观察对实际样品检测的符合率情况。
结果ccEA具有良好的选择性;对7种质控菌株检验结果的分析,ccEA与VRBA和AgarⅡ比较无统计学意义;ccEA比AgarI长出菌落数略多,有统计学意义。
对13种无菌样品中添加大肠杆菌或大肠菌群检验结果的分析,ccEA比VRBA长出菌落数略多,有统计学意义;ccEA与AgarI和AgarⅡ比较无统计学意义。
对4种实际样品中大肠菌群检验结果的分析,ccEA与VRBA、AgarI和AgarⅡ比较无统计学意义;大肠菌群经验证总体符合率分别为90%、71.88%、86.25%和81.25%,即符合率大小为ccEA>AgarI>AgarⅡ>VRBA。
对4种实际样品中大肠杆菌检验结果的分析,ccEA与AgarI和AgarII比较无统计学意义;大肠杆菌经验证总体符合率均为100%。
结论本实验室研究试制的显色培养基ccEA优于经典培养基VRBA并与国外两种同类显色培养基AgarI和AgarII总体检测效果无统计学意义。
【关键词】培养基;大肠杆菌;肠杆菌科Eval岫d蚰帆e廊ctsofchromogenic删锄啪inrapiddetec6蚰of仂厦细硼and眈^B枷缸cD矗£U胞帆垂i,形UQing巾i昭,∞,铂i—k,册zk凡一埘e几G∞,lgdD愕日眦砌i舰rD6谢&i&死以酝,血正,‰n砌Du5JOD70,吼iM【Abstmct】Obj∞6veToevaluatetlledetectiveemcacyofchmmogeIliccoz扣肌a11d瓜c7如庇^施c0如Agar(ccEA).MethodsAnewchromogenicmediumccEApreparedbyHu趴kailaboratorywasusedtocompaTewi出aclassicalmediumofvioletredbileagar(VRBA),andothertw。
念珠菌属念珠菌属真菌显色培养基真菌显色培养基真菌显色培养基((培养法培养法)) 使用说明书使用说明书【产品名称】念珠菌属真菌显色培养基(培养法)。
【组成、型号规格】组成型号规格 培养皿规格琼脂培养基、一次性塑料培养皿P07217cm【预期用途】适用于念珠菌属真菌分离培养及初步鉴定。
【检验原理】在培养基中加入检测某种菌种的特异性酶底物,该底物为人工合成由产色基团和微生物可代谢物质组成,通常为无色,但在特异性酶作用下,游离出发色基团并显示一定颜色,直接观察菌落颜色即可对菌种做出鉴定。
【主要组成成份】每1000mL 念珠菌属真菌显色琼脂含:a) 琼脂 (BR级) 15g, b) 蛋白胨 (BR级) 10.2g, c) 色素 (AR级) 22.0g, d) 氯霉素 (化学品) 0.5g。
e) 蒸馏水 1000mL【储存条件及有效期】2℃~8℃保存,切勿冻藏。
在储存条件下,自生产之日起有效期60天。
【样本要求】1、 各种分泌物——包括泌尿生殖道分泌物、耳垢、痰及其它2、 皮肤的角质性物质3、 脓汁及渗出物4、 血液及体液——体液包括胸水、腹水、脑脊液、淋巴穿刺液等5、 粪便和尿液6、 活组织标本7、 环境中各种标本材料注意:(1) 采取部位要恰当:感染的类别不同,采取的标本也不同。
如为深部真菌感染可根据病的种类采取脓汁,痰液、血液、脑脊液等。
(2) 标本应新鲜:特别是深部真菌标本尽量在取材后立即检查,最长不得超过两小时。
如不能立即送检则必须放入冰箱中保存,尽速送检。
(3) 应在用药前采集标本,如已用药则须停一段时间药后再采集。
(4) 标本的量要充足,血液和脑脊液不得少于5ml,胸腔液不得少于20ml。
(5) 避免污染杂菌,须严格进行无菌操作。
【检验方法】1. 将培养基复温至常温25℃;2. 将标本接种于培养基琼脂面上;3. 35℃培养24~48小时。
【检验方法的局限性】本产品仅适用于念珠菌属真菌分离培养及鉴定用。
Ham's F-12K粉末培养基使用说明书产品简介Ham's F-12K培养基是Ham's F-12营养混合物的Kaighn's改进型,在Ham's F-12的基础上提高了氨基酸和丙酮酸的浓度,降低了葡萄糖的用量,并修改了盐的成分和含量(Konigsbergs)。
Ham's F-12K培养基最初设计用于培养原代人肝细胞以及分化的大鼠和鸡的细胞。
本产品含有多类细胞培养所需的氨基酸、维生素、无机盐等多种成分,但不含蛋白质、脂类或任何生长因子,故此产品需搭配血清或无血清添加物使用。
产品规格与保存产品名称货号产品规格保存条件保存期限5x1L1x10L Ham's F-12K粉末培养基PM150910P1x50L 2~8℃密闭、避光36个月产品使用方法【1】于一容器中倒入约90%超纯水,将本品一袋或者称取1L用量,全部倒入该容器中,用少量超纯水将袋内残留粉末洗出。
【2】搅拌30min使所有成分完全溶解,待溶液澄清后,加入2.5g碳酸氢钠(分析纯),继续搅拌5-10min至溶解。
【3】加超纯水定容至1L。
【4】必要时用1mol/L氢氧化钠溶液或1mol/L盐酸溶液调整PH值至7.20-7.30,由于过滤会使培养基PH值稍微偏高,因此此处比目的PH值(7.20-7.40)要低一些。
【5】用孔径为0.2μm的滤膜正压过滤除菌(注意无菌操作)。
【6】过滤结束可以取少许液体培养基进行菌检,待合格后再使用。
此时液体培养基保质期为1年,储存条件为2~8℃。
备注:该使用方法以1L规格为例,其他规格使用方法按照对应规格加入对应量的碳酸氢钠以及定容到对应规格的体积即可。
常规成分说明形态粉末L-谷氨酰胺2mMD-葡萄糖1260mg/LHEPES缓冲剂无酚红指示剂 3.0mg/L注意事项1、为了您的安全和健康,请穿实验服并戴一次性手套及口罩操作;2、为保持本产品的最佳使用效果,请务必按照建议的储存条件进行保存;3、本产品仅供科学研究或进一步生产使用,不可用于临床诊断或治疗。
实验用培养基配制1.牛肉膏蛋白胨培养基(用于细菌培养)牛肉膏3g,蛋白胨10g,NaCl 5g, 水1000mL,pH7.4~7.62. 高氏 1 号培养基(用于放线菌培养) 可溶性淀粉20g , KNO3 1g, NaCl 0.5g,K2HPO4-·3H2O 0.5g, MgSO4·7H2O 0.5g, FeSO4·7H2O 0.01g, 水1000mL, pH7.4~7.6。
配制时注意,可溶性淀粉要先用冷水调匀后再加入到以上培养基中。
3.马丁氏(Martin)培养基(用于从土壤中分离真菌)K2HPO4 1g, MgSO4·7H2O 0.5g,蛋白胨5g, 葡萄糖10g, 1/3000 孟加拉红水溶液100mL,水900mL, 自然pH, 121℃湿热灭菌30min. 待培养基融化后冷却55~60℃时加入链霉素(链霉素含量为30μg/mL).4. 马铃薯培养基(PDA)(用于霉菌或酵母菌培养) 马铃薯(去皮)200g, 蔗糖(或葡萄糖)20g, 水1000mL, 配制方法如下: 将马铃署去皮,切成约2cm2 的小块,放入1500mL 的烧杯中煮沸30min, 注意用玻棒搅拌以防糊底, 然后用双层纱布过滤, 取其滤液加糖,再补足至1000mL, 自然pH. 霉菌用蔗糖, 酵母菌用葡萄糖.5. 察氏培养基(蔗糖硝酸钠培养基)(用于霉菌培养) 蔗糖30g, NaNO3 2g, K2HPO41g,MgSO4·7H2O 0.5g, KCl 0.5g, FeSO4·7H2O 0.1g, 水1000mL, pH7.0~7.26. Hayflik 培养基(用于支原体培养) 牛心消化液(或浸出液)1000mL,蛋白胨10g, NaCl5g,琼脂15g, pH7.8~8.0, 分装每瓶70mL, 121℃湿热灭菌15min,待冷却至80℃左右,每70mL 中加入马血清20mL,25%鲜酵母浸出液10mL, 15 醋酸铊水溶液2.5mL, 青霉素G 钾盐水溶液(20 万单位以上)0.5mL, 以上混合后倾注平板. 注意:醋酸铊是极毒的药品,需特别注意安全操作.7.麦氏(McCLary)培养基(醋酸钠培养基)葡萄糖0.1g, KCl 0.18g,酵母膏0.25g,醋酸钠0.82g, 琼脂l.5g,蒸馏水l00mL。
[沙氏葡萄糖蛋白胨琼脂,沙堡弱培养基,SDA](一)组成葡萄糖 40.0g蛋白胨 10.0g琼脂12.0~15.0g蒸馏水 1000ml(二)制法上述混合后加入200mg氯霉素,121摄氏度10分钟灭菌后备用。
(三)目的是常用的分离或保存菌种的培养基。
[沙氏液基,SDB](一)组成葡萄糖 40.0g蛋白胨 10.0g蒸馏水 1000ml(二)制法上述混合后加入200mg氯霉素,121摄氏度10分钟灭菌后备用。
[加抗生素沙氏葡萄糖蛋白胨琼脂基,SDA with antibiotic](一)组成葡萄糖 40.0g蛋白胨 10.0g琼脂12.0~15.0g蒸馏水 1000ml(二)制法上述混合后加入200mg氯霉素。
250mg放线菌酮,121摄氏度10分钟灭菌后备用。
[改良沙氏葡萄糖蛋白胨琼脂基,modified SDA](一)组成葡萄糖 20.0g蛋白胨 10.0g琼脂12.0~15.0g蒸馏水 1000ml(二)制法上述混合后121摄氏度10分钟灭菌后备用。
(三)目的保存菌种培养基。
[马铃薯葡萄糖琼脂,PDA](一)组成马铃薯 200.0g葡萄糖 20.0g琼脂12.0~15.0g蒸馏水 1000ml(二)制法先将马铃薯洗净去皮切片,加水180ml,煮沸30分钟后过滤,再加葡萄糖、琼脂,将过滤液补足到1000ml,121摄氏度灭菌后备用。
(三)用途此培养基是培养真菌较好的培养基,同时也是鉴定真菌较好的培养基之一。
鉴定皮肤癣菌一般不用此培养基。
[玉米吐温80琼脂,CMA with Tw80](一)组成玉米粉 40.0g琼脂15.0g蒸馏水 1000ml吐温80 10ml(二)制法先将玉米粉混于水中,65摄氏度水浴一小时,过滤,再补足水量,然后加入琼脂和吐温80,121摄氏度10分钟灭菌后备用。
(三)用途用于观察白念珠菌厚壁孢子及假菌丝;红色毛癣菌在此培养基产色素较好。
[米饭培养基rice grain medium](一) 组成大米 300.0g蒸馏水 1000ml(二)制法将3g大米放入试管中,加入10ml蒸馏水,高压121摄氏度10分钟灭菌后备用。
马拉色菌显色培养基使用说明书
用于马拉色菌的检测。
组分
琼脂15.0 g/L 蛋白胨和酵母粉38.0 g/L 氯霉素0.5 g/L
色素 2.8 g/L
pH值6.1±0.2
操作
1、取瓶内干粉56.3 g溶于1000 mL去离子水的洁净三角瓶中,添加1g/L
甘油和0.5g/L吐温60,充分搅拌混匀。
也可根据需要按照56.3 g/L的比例扩大或缩小制备培养基的量。
2、加热至100℃,不停搅拌,使其完全溶解。
切勿加热超过100℃,切勿
121℃高压灭菌。
若使用微波炉加热,应将培养基加热沸腾,立即移出,轻轻摇匀,再放入微波炉加热,观察小气泡变为大气泡,直至完全溶解即可。
切勿使培养基溢出。
3、加热后的培养基冷却至45℃~50℃,轻轻地摇动均匀,倾注平皿,使其
凝固,晾干备用。
保存该成品平板在室温可保存一天或在冰箱内贮存1个月(2℃~8℃,避光)。
接种
划线或涂布接种(冰箱内保存的平板使用前应恢复至室温),在30℃~37℃恒温条件下需氧培养72h。
结果
性能及局限
对糠秕马拉色菌的特异性和灵敏度接近100%(Kaneko et al. 2007)。
最终鉴定需要做附加实验。
贮存条件
干粉需保存于15℃~30℃干燥环境中,在有效期前使用。
污染处理
使用过的培养基需要在121℃灭菌至少20分钟才可以按照有关规定丢弃。
附:供体外诊断使用,产品须专业人员操作。